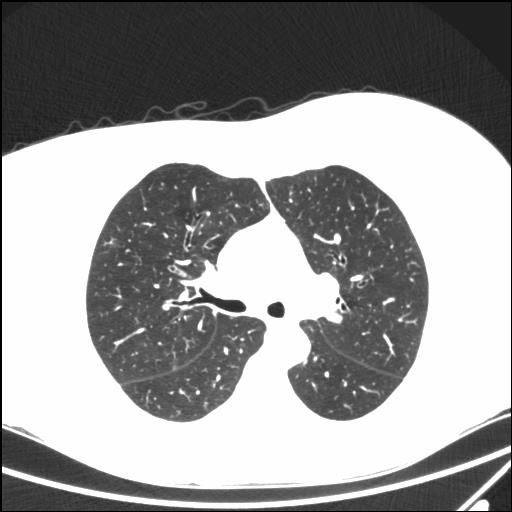

Раскладка: Русская
-
 ЦИФРОВОЙ РЕНТГЕН НА ДОМУ
ЦИФРОВОЙ РЕНТГЕН НА ДОМУ
8-495-22-555-6-8при переломе шейки бедра и пневмонии от компании МосРентген Центр - партнера Института имени Склифосовскогоподробно -
 РЕНТГЕН ПОД КЛЮЧЛицензирование рентгеновских кабинетовподробно
РЕНТГЕН ПОД КЛЮЧЛицензирование рентгеновских кабинетовподробно -
 Продажа цифрового рентгенаРентген дигитайзер AGFA CR12-X - оцифровщик рентгеновских снимковподробно
Продажа цифрового рентгенаРентген дигитайзер AGFA CR12-X - оцифровщик рентгеновских снимковподробно